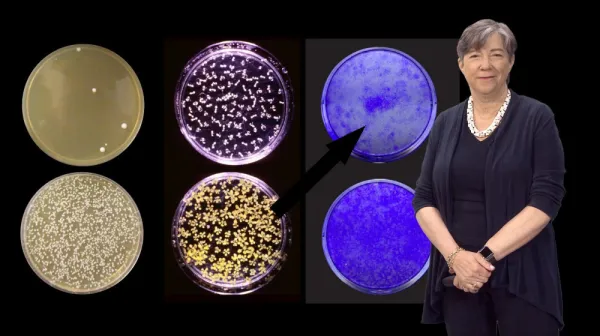
Головоломка диагностики: угадайте диагноз в этих странных медицинских случаях

Тег: заболевания
Уникальная вакцина против всех респираторных болезней уже в пути
15 апреля, 07:18
Научные исследования в области разработки универсальной вакцины против респираторных патогенов достигли значительного прогресса. Сегодня ученые всего мира борются не просто с отдельными вирусами ...
Science history: Doctor hypothesizes that 'transmissible proteins' can cause disease, contradicting a 'central dogma' of molecular biology — April 9, 1982
11 апреля, 08:26
Неожиданный враг: как редкая водная аллергия поставила в тупик педиатров
02 апреля, 07:28
Диагностика аллергических реакций у подростков зачастую представляет собой сложную задачу, особенно когда классические причины — пыльца, пищевые продукты или медикаменты — исключены. Одним из сам...
Антипрививочные настроения увеличивают риск хронических заболеваний у американцев
17 февраля, 07:40
Обеспеченность населения вакцинами — один из ключевых факторов профилактики инфекционных болезней. Однако в США растет число людей, выступающих против вакцинации, что ведет к увеличению распростр...
Ночные совы рискуют сердцем: что скрывается за этой загадкой
10 февраля, 07:18
В современном мире люди всё чаще сталкиваются с вопросами, связанными с особенностями своих биоритмов и привычками сна. Одной из наиболее обсуждаемых тем является связь между хронотипом человека ...
Почему мужчины заболевают сердечно-сосудистыми раньше женщин
06 февраля, 23:51
Исследования показывают, что мужчины подвергаются риску развития сердечно-сосудистых заболеваний (ССЗ) в среднем на 7 лет раньше женщин. Эта разница вызывает множество вопросов у ученых и врачей:...
Головоломка диагностики: угадайте диагноз в этих странных медицинских случаях
01 февраля, 11:10
Каждую неделю в рамках серии Диагностическая дилемма журнал Live Science публикует уникальные случаи из практики медицины, вызывающие вопросы у специалистов и любителей науки. Эти истории отличаю...